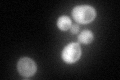
YBR149W
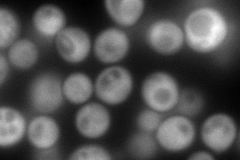
YBR149W
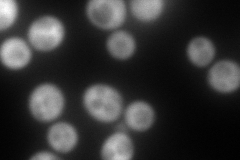
YBR149W
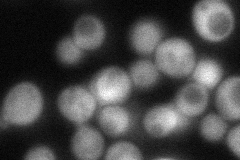
YBR149W
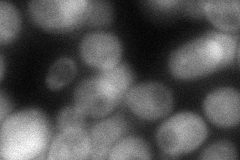
YBR149W
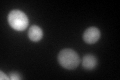
YBR149W
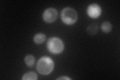
YBR149W

View description
NADP+ dependent arabinose dehydrogenase, involved in carbohydrate metabolism; purified as homodimer; naturally occurs with a N-terminus degradation product
Localization:
Intensity:
Fold change:
Significance:
-
C’ GFP library in SD
cytosol77.35 -
N' NOP1pr-GFP in SD
cytosol308.383 -
N' TEF2pr-mCherry in SD
cytosol341.669 -
N' NATIVEpr-GFP in SD
cytosol70.3061 -
N' TEF2pr-VC and Cyto-VN in SD
cytosol75.4929 -
C’ GFP library in SD+DTT
cytosol109.311.41Yes -
C’ GFP library in SD+H2O2

nucleusN/AN/ANo -
C’ GFP library in Starvation Media
nucleusN/AN/AYes -
C’ GFP library on the background of Pup2-DaMP

cytosol -
C’ GFP library on the background of CCT mutant

cytosol89.65871.159No
